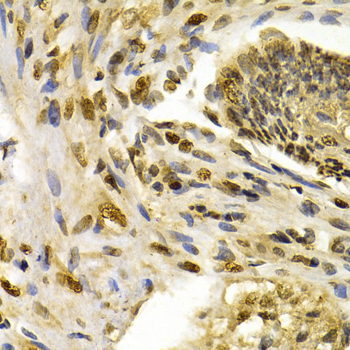
A2203: image 3

For quotations, please use our online quotation form, and you may also contact us by
sales@neoscientific.com
+1-888.733.6849
+1-617.299.7367 (Int’l)
+1-888.733.6849
+1-617.299.7367 (Int’l)
| Reactivity | Human Mouse |
| Tested applications | WB IHC IF |
| Recommended Dilution | WB 1:500 - 1:2000 IHC 1:50 - 1:200 IF 1:50 - 1:200 |
| Calculated MW | 117kDa |
| Observed MW | Refer to Figures |
| Immunogen | Recombinant protein of human IFIH1 |
| Storage Buffer | Store at -20℃. Avoid freeze / thaw cycles. Buffer: PBS with 0.02% sodium azide, 50% glycerol, pH7.3. |
| Concentration | b |
| Synonym | Hlcd; IDDM19; MDA-5; MDA5; MGC133047; |

Western blot analysis of extracts of THP-1 cell line, using IFIH1 antibody.

Immunohistochemistry of paraffin-embedded human colon cancer using IFIH1 antibody at dilution of 1:200 (400x lens).
Immunohistochemistry of paraffin-embedded human esophagus cancer using IFIH1 antibody at dilution of 1:200 (400x lens).

Immunofluorescence analysis of U2OS cell using IFIH1 antibody. Blue: DAPI for nuclear staining.

Immunofluorescence analysis of A549 cell using IFIH1 antibody. Blue: DAPI for nuclear staining.
cts viral dsRNA and two amino-terminal caspase recruitment domains (CARD) that are required for triggering downstream signaling (4-7). Rig-I binds both dsRNA and viral ssRNA that contains a 5'-triphosphate end not seen in host RNA (8,9). Though structurally related, Rig-I and MDA-5 detect a distinct set of viruses (10,11). The CARD domain of the helicases, which is sufficient to generate signaling and IFN production, is recruited to the CARD domain of the MAVS/VISA/Cardif/IPS-1 mitochondrial protein, which triggers activation of NF-κB, TBK1/IKKε, and IRF-3/IRF-7 (12-15).
N/A